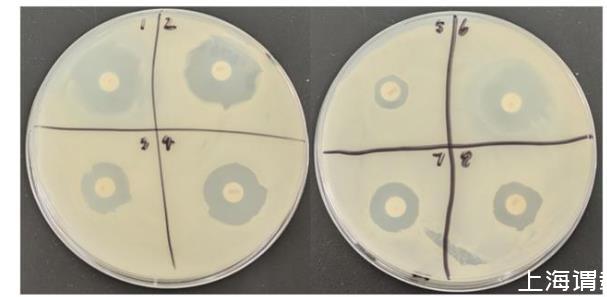

牛源解淀粉芽孢杆菌产纤维素酶活力测定、抗逆性及药敏试验(二)
1.3产酶条件优化
对产酶能力强的菌株进行单因素试验:设定发酵培养基初始pH为6,接种量为1%,发酵时间分别为12、24、36、48、60 h,测定发酵时间对菌株产酶能力的影响;设定发酵培养基的初始pH为6,接种量分别为1%、2%、3%、4%、5%,发酵时间为前面得出的最佳发酵时间(48 h),测定接种量对菌株产酶能力的影响;设定发酵培养基初始pH分别为5、6、7、8、9,接种量和发酵时间为前面得出的最佳接种量(4%)和最佳发酵时间(48 h),测定发酵培养基初始pH对菌株产酶能力的影响。
1.4药敏试验
选择8种抗菌药物(氯霉素、新生霉素、阿莫西林、新霉素、庆大霉素、红霉素、链霉素、利福平),以纸片法对待测菌株进行药物敏感性测定,以了解待测菌株对抗菌药物的耐药性。选取药敏纸片,按照药敏纸片扩散法操作步骤进行相关菌株的药敏试验。
1.5抗逆性试验
1.5.1人工胃液耐受性
将待测菌株接种到NB培养基中,摇瓶发酵24 h,将待测菌株发酵液按接种量10%接种于10 mL pH分别为2.0、4.0的人工胃液中处理3 h,以0 h的样品作为对照,计算菌株存活率。
1.5.2人工肠液耐受性
将待测菌株接种到NB培养基中,摇瓶发酵24 h,取1 mL待测菌株发酵液接种到9 mL胆盐浓度分别为0.1%、0.2%、0.3%的人工肠液中处理3 h,以0 h的样品作对照,计算菌株存活率。
1.6体外抑菌试验
采用琼脂扩散法进行体外抑菌试验。以大肠杆菌、结核杆菌、金黄色葡萄球菌作为指示菌,吸取100μL病原菌菌液,稀释、涂布后打孔(打孔器直径9 mm),再分别吸取待测菌株的发酵液、上清液、菌悬液100μL加入孔内,置于30℃恒温培养箱培养1 d,重复3次,测量抑菌圈直径,计算圈径比(抑菌圈直径/打孔直径)。
1.7溶血活性试验
以金黄色葡萄球菌为阳性对照,将待测菌株及金黄色葡萄球菌划线接种于哥伦比亚血琼脂培养基上,37℃培养1 d,观察有无溶血圈产生。
1.8全基因组测序分析
采用三代测序的方法进行全基因组测序分析(委托南宁国拓生物科技有限公司完成),使用prokka工具对细菌基因组进行注释,通过比对CAZy、GO、VFDB、CARD数据库,对细菌基因组进行注释。
1.9数据处理及统计学分析
用Excel 2016软件进行数据处理,试验结果使用GraphPad Pism 9.5软件进行单因素方差分析及作图。
2结果与分析
2.1目标菌株的初筛结果
根据单菌落大小、形态、颜色挑取不同形态的细菌进行纯化,最终选定15株细菌。采用刚果红染色法对选定的菌株进行初筛,得到1株能产生透明圈的菌株(图1),将其命名为GXUN13068-1,测量其透明圈直径为31.23 mm,菌落直径为16.17 mm,EI为1.93。

图1菌株GXUN13068-1水解透明圈
2.2菌株鉴定结果
2.2.1菌株形态特征
菌株GXUN13068-1菌落表面有褶皱,菌落颜色为灰白色,菌落边缘呈不规则状,表面干燥呈磨砂样,有火山口状凸起(图2-a);经革兰氏染色,显微镜观察菌体为革兰氏阳性菌,呈蓝紫色,短杆状(图2-b);扫描电子显微镜下测量菌体长约1.52μm,宽约0.65μm(图2-c)。

图2菌株GXUN13068-1的菌落形态(a)、革兰氏染色(b)及扫描电子显微镜镜检形态(c)
2.2.2生理生化特征
菌株GXUN13068-1的生理生化鉴定结果生理生化鉴定结果见表1。根据鉴定结果,该菌株符合芽孢杆菌的生理生化特征。

表1菌株GXUN13068-1的生理生化鉴定结果
2.2.3菌株16S rDNA的序列分析
将菌株GXUN13068-1的16S rDNA测序结果上传至EzBioCloud进行比对分析,结果显示,菌株GXUN13068-1与解淀粉芽孢杆菌(Bacillus amyloliquefaciens)的序列相似性为99.86%。
2.3菌株GXUN13068-1产酶发酵条件的优化结果
当发酵培养基的初始pH为6,接种量为1%时,发酵时间对菌株GXUN13068-1产酶能力的影响如图3所示。当发酵时间为48 h时,菌株GXUN13068-1的产酶能力达到最大,所产纤维素酶活力为103.24 U/mL。

图3发酵时间对菌株GXUN13068-1产酶能力的影响数据柱标注不同小写字母表示处理间有显著差异(P<0.05)。下图同。
当发酵培养基的初始pH为6,发酵时间为48 h时,接种量对菌株GXUN13068-1产酶能力的影响如图4所示。当接种量为4%时,菌株GXUN13068-1的产酶能力达到最大,所产纤维素酶活力为113.23 U/mL。

图4接种量对菌株GXUN13068-1产酶能力的影响
当接种量为4%,发酵时间为48 h时,发酵培养基初始pH对菌株GXUN13068-1产酶能力的影响如图5所示。当发酵培养基初始pH为9时,菌株GXUN13068-1的产酶能力达到最大,所产纤维素酶活力为126.37 U/mL。

图5发酵培养基初始pH对菌株GXUN13068-1产酶能力的影响
2.4药敏试验结果
菌株GXUN13068-1对8种抗菌药物的敏感性如图6和表2所示。根据美国临床标准委员会(NCCLS)的试验要求和标准,菌株GXUN13068-1对新生霉素、庆大霉素、氯霉素、红霉素、链霉素均表现为敏感,对新霉素表现为中度敏感,对利福平和阿莫西林表现出耐药性。
图6菌株GXUN13068-1的药敏试验结果1:氯霉素chloramphenicol;2:新生霉素neomycin;3:新霉素neomycin;4:庆大霉素gentamicin;5:阿莫西林amoxicillin;6:红霉素erythromycin;7:链霉素streptomycin;8:利福平rifampicin。

表2菌株GXUN13068-1对8种抗生素的敏感性
S:敏感;I:中介;R:耐药。
2.5抗逆性试验结果
2.5.1人工胃液耐受性
菌株GXUN13068-1对人工胃液的耐受性见表3。菌株GXUN13068-1的存活率随着人工胃液pH的升高有下降趋势,pH 2.0和pH 4.0的人工胃液处理3 h的存活率均在70%以上,说明该菌株对人工胃液具有良好的耐受性。

表3菌株GXUN13068-1对人工胃液的耐受性
2.5.2人工肠液耐受性
菌株GXUN13068-1对人工肠液的耐受性见表4。经胆盐浓度分别为0.1%、0.2%、0.3%的人工肠液处理3 h后,菌株GXUN13068-1的存活率均在85%以上,说明该菌株对人工肠液有良好的耐受性。

表4菌株GXUN13068-1对人工肠液的耐受性
相关新闻推荐
2、微量量热法研究金银花与灰毡毛忍冬对志贺痢疾杆菌生长代谢的影响(一)
3、YOLO浮游菌落识别模型 VS µCount3D微生物计数仪
